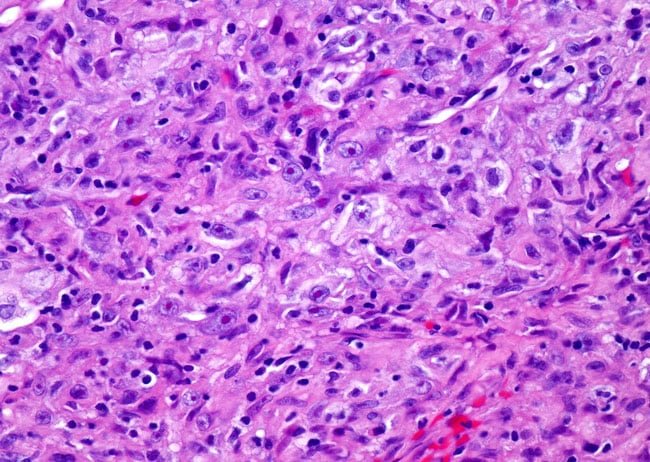
Sarcomatoid Mesothelioma Cells

Sarcomatoid mesothelioma is a rare, aggressive type of mesothelioma, mostly caused by asbestos exposure. It accounts for just 10% to 20% of mesothelioma diagnoses and spreads more readily and aggressively than the epithelioid cell type.[1][2] Treating sarcomatoid mesothelioma is more difficult, and life expectancy is a year or less.
What Are Sarcomatoid Cells?
Any cancer that arises from cells of the mesenchyme tissue type is called a sarcoma. The cells of sarcomatoid cancer come from tissues of the:
- Circulatory system
- Lymphatic system
- Bone, cartilage, or other connective tissue
Sarcomatoid cells of mesothelioma tumors have certain characteristics that distinguish them from epithelial cells:[3]
- They are shaped like tiny spindles with elongated and enlarged nuclei.
- Some cells may even have more than one nucleus.
- These cells are less firmly attached to each other than epithelial cells and are more likely to spread to other areas of the body.
What Is Sarcomatoid Mesothelioma?
When the majority of cells in mesothelioma tumors are the sarcomatoid type, the diagnosis is sarcomatoid mesothelioma. Only 10% to 20% of mesothelioma cases are sarcomatoid. Most of these are pleural mesothelioma.
This is the rarest cell type for mesothelioma and also the most aggressive. It responds poorly to treatment. Most patients with this type are not eligible for surgery and have a very poor prognosis.
What Causes Sarcomatoid Mesothelioma?
Asbestos exposure is the number one cause and contributing factor for all types of mesothelioma. It may not be the only factor, though, as some people receive a diagnosis without any known exposure.
Asbestos is most strongly associated with pleural mesothelioma, which affects the tissue around the lungs. Because most cases of sarcomatoid mesothelioma are pleural, the vast majority can be attributed to past asbestos exposure. For most people, this occurred in the workplace decades before symptoms appeared.
What Are the Signs of Sarcomatoid Mesothelioma?
Sarcomatoid mesothelioma causes symptoms similar to other types of mesothelioma. For pleural mesothelioma, this means a cough, difficulty breathing, wheezing, chest pains, and eventually fever, fatigue, and weight loss in later stages.
Sarcomatoid peritoneal mesothelioma is rare. When it does occur, it causes abdominal swelling and fluid build-up, abdominal pain, gastrointestinal symptoms, weight loss, fever, and fatigue.
Sarcomatoid Mesothelioma Sub-Types
There are also several sub-types of sarcomatoid cells that may be seen in this type of mesothelioma:[4][5][6][7]
- Desmoplastic cells are bland in appearance without many distinguishing characteristics. This subtype is very difficult to diagnose. This type of growth can be mistaken for a benign condition when, in reality, it is characteristic of mesothelioma tumor growth into fibrous tissues.
- Lymphohistiocytoid cells are large and very rare, accounting for just 1% of all mesothelioma diagnoses.
- Heterologous mesothelioma occurs when other cell types are present in addition to the original mesothelial cells. For example, tumors may contain bone cells in addition to mesothelial cells.
- Rhabdomyoblastic Differentiation is an extremely rare subtype of sarcomatoid mesothelioma. Rhabdomyoblastic differentiation contains a specific type of muscle cell known as a rhabdomyoblast. Rhabdomyoblasts are early muscle cells that develop into full skeletal muscle tissue.
How Is Sarcomatoid Mesothelioma Diagnosed?
To diagnose any type of mesothelioma, including sarcomatoid:
- The first step is a basic physical examination.
- The physical exam is typically followed by an imaging scan: a chest X-ray, CT scan, or MRI.[8]
- If imaging scans show abnormal tissues that could be potential tumors, the next diagnostic step is a biopsy. During a biopsy, a thin needle is inserted to obtain a fluid or tissue sample.
- Fluid samples rarely show sarcomatoid cells, so for a full diagnosis, a tissue sample is necessary.[4]
- A pathologist examines the cells to determine if the tissue is cancerous and if it is mesothelioma. This step is especially important for distinguishing between sarcomatoid and epithelioid mesothelioma.
- At this point, the pathologist will also determine if the cancer is epithelial, sarcomatoid, or biphasic.
The Dangers of Misdiagnosing Sarcomatoid Mesothelioma
Sarcomatoid mesothelioma is easy to misdiagnose as several fibrous conditions, both cancerous and noncancerous, including:[9]
- Localized fibrous tumors
- Pleural liposarcoma
- Renal cell carcinoma
- Fibrous histiocytoma
- Fibrous pleurisy
Misdiagnosis is a serious concern with any type of mesothelioma, particularly with the sarcomatoid cell type. Because this is the most aggressive type, early diagnosis is essential for improved outcomes.
A misdiagnosis delays the correct diagnosis, which delays treatment. A patient can lose months of their life as a result.
Researchers continue to work on ways to not just treat mesothelioma more effectively, but also to diagnose it more accurately. An important line of investigation is immunohistochemistry.
Immunohistochemistry is a more precise strategy for identifying cell types and diagnosing mesothelioma subtypes. This technique uses diagnostic markers specific to cell type to stain tissue.
The markers are antigens and antibodies, proteins used by the immune system to identify and target pathogens. It provides a more accurate way to diagnose cell types.
How Is Sarcomatoid Mesothelioma Treated?
Treatment for sarcomatoid mesothelioma depends on the individual patient. It is usually multimodal, involving more than one type of treatment.
Unlike epithelial and biphasic mesothelioma, most specialists do not classify this type of mesothelioma as resectable. This means that sarcomatoid mesothelioma cannot be treated surgically.[4]
The cancer spreads too quickly for surgery to be able to remove tumors in their entirety. Sarcomatoid mesothelioma tumors tend to grow into the chest wall, making removal difficult and risky.
Without surgery as a treatment option, specialists must rely on other strategies:
Chemotherapy
The official guidelines for treating mesothelioma recommend chemotherapy for all stages of sarcomatoid mesothelioma. Typical chemotherapy drugs include pemetrexed, cisplatin, and sometimes gemcitabine.[10]
Experts also recommend using bevacizumab in addition to chemotherapy for sarcomatoid patients.[10]
A review of thirty sarcomatoid malignant pleural mesothelioma trials with various medications showed fewer responses in patients with sarcomatoid histology than in the other mesothelioma subtypes.[11] In other words, chemotherapy is the first-line treatment for these patients, but it has limited effectiveness.
Radiation Therapy
Official guidelines for treatment recommend the use of radiation therapy in sarcomatoid patients in certain situations. It can be used after chemotherapy and as part of palliative care.[10] Radiation shrinks tumors, which can make patients more comfortable.
Clinical Trials
Treatment options are extremely limited for sarcomatoid mesothelioma. Some patients may want to enroll in clinical trials to access experimental treatments. Clinical trials test novel treatments that are not generally available yet.
Not many trials recruit sarcomatoid patients, but some do. Some of the recent studies that included sarcomatoid mesothelioma investigated:[12]
- Immunotherapy drugs in combination with chemotherapy
- Immunotherapy drugs alone
- New targeted medications
- Second-line treatment using a new chemotherapy drug
- Enzyme-blocking drugs to halt cancer cell growth
- Photodynamic therapy
If you’re interested in clinical trials, talk to your doctor about whether you qualify.
Palliative Treatment
Extending life expectancy is a real challenge with sarcomatoid mesothelioma. Many patients choose to focus on palliative care. This is any kind of treatment, procedure, or therapy designed to improve quality of life.
Palliative care options for mesothelioma include:
- Minor surgical procedures, such as draining fluid from the chest or abdominal cavities
- Radiation or chemotherapy to shrink tumors
- Pain management, including medication
- Complementary and alternative medicine
- Nutrition and supplements
- Mental health care and counseling
What Is the Outlook for Sarcomatoid Mesothelioma?
Prognosis varies depending on individual factors such as the stage of cancer, the patient’s age, lifestyle habits, and overall health. Overall, the prognosis for sarcomatoid mesothelioma is generally poor.
Studies indicate that a diagnosis of sarcomatoid mesothelioma, even with surgical treatment, results in a median survival time of just four months.[4] Chemotherapy and radiation therapy may extend life expectancy better than surgery, but they have minimal effect.
Can Anyone Survive Sarcomatoid Mesothelioma?
Unfortunately, this is extremely rare. Sarcomatoid mesothelioma is very aggressive and is most often diagnosed in later stages. Treatment options are limited and focus mostly on extending life expectancy and palliative care.
Can I Improve My Prognosis at All?
Although sarcomatoid mesothelioma is generally terminal, you can still take steps to get a better outcome:
- Push for an accurate diagnosis, getting a second or third opinion if necessary.
- Seek out experienced specialists in mesothelioma, both for diagnosis and treatment.
- Start treatment as soon as possible.
- Follow your medical team’s directions.
- Discuss palliative care with your doctor to explore ways to improve your quality of life.
- Enroll in clinical trials to try experimental treatments if you qualify.
If you have symptoms of mesothelioma or have been exposed to asbestos, an early and accurate diagnosis is crucial for receiving the best possible prognosis. The earlier you receive a diagnosis and start treatment, the better your life expectancy and comfort level.

Mary Ellen Ellis
WriterMary Ellen Ellis has been the head writer for Mesothelioma.net since 2016. With hundreds of mesothelioma and asbestos articles to her credit, she is one of the most experienced writers on these topics. Her degrees and background in science and education help her explain complicated medical topics for a wider audience. Mary Ellen takes pride in providing her readers with the critical information they need following a diagnosis of an asbestos-related illness.

Pinar Kanlikilicer, Ph.D.
Medical Reviewer and EditorDr. Pinar Kanlikilicer has a PhD in Biomedical Engineering. She completed her 5-years of postdoctoral training in the Department of Experimental Therapeutics at MD Anderson Cancer Center. She is currently working in the field of cancer as a research scientist.
References
- Rossini, M., Rizzo, P., Bononi, I., Clementz, A., Ferrari, R., Martini, F., and Tognon, M.G. (2018, April 3). New Perspectives on Diagnosis and Therapy of Malignant Pleural Mesothelioma. Front. Oncol. https://doi.org/10.3389/fonc.2018.00091.
Retrieved from: https://www.frontiersin.org/articles/10.3389/fonc.2018.00091/full - Klebe, S., Brownlee, N.A., Mahar, A., Burchette, J.L., Sporn, T.A., Bollmer, R.T., and Roggli, V.L. (2010). Sarcomatoid Mesothelioma: A Clinical-Pathologic Correlation of 326 Cases. Modern Pathology. 23, 470-9.
Retrieved from: https://www.nature.com/articles/modpathol2009180 - Moffitt Cancer Center. (n.d.). Sarcomatoid Mesothelioma.
Retrieved from: https://moffitt.org/cancers/mesothelioma/types/sarcomatoid-mesothelioma/ - Kindler, H.L., Ismaila, N., Armato, S.G., Bueno, R., Hesdorffer, M., Jahan, T., Jones, C.M., Miettinen, M., Pass, H., Rimner, A., Rusch, V., Sterman, D., Thomas, A., and Hassan, R. (2018). Treatment of Malignant Pleural Mesothelioma: American Society of Clinical Oncology Clinical Practice Guideline. J. Clin. Oncol. 36(13), 1343-75.
Retrieved from: https://ascopubs.org/doi/pdf/10.1200/JCO.2017.76.6394 - Berg, K.B. and Churg, A. (2017, September). GATA3 Immunohistochemistry for Distinguishing Sarcomatoid and Desmoplastic Mesothelioma From Sarcomatoid Carcinoma of the Lung. Am. J. Surg. Pathol. 41(9), 1221-5.
Retrieved from: https://www.ingentaconnect.com/content/wk/ajsp/2017/00000041/00000009/art00008 - Marchevsky, A.M., LeStang, N., Hiroshima, K., Pelosi, G., Attanoos, R., Churg, A., Chirieac, L., Dacic, S., Husain, A., Khoor, A., Klebe, S., Lantuejoul, S., Roggli, V., Vignaud, J-M., Weynard, B., Sauter, J., Henderson, D., Nabeshima, K., and Galateau-Salle, F. (2017, September). The Differential Diagnosis Between Pleural Sarcomatoid Mesothelioma and Spindle Cell/Pleomorphic (Sarcomatoid) Carcinomas of the Lung: Evidence-Based Guidelines from the International Mesothelioma Panel and the MESOPATH National Reference Center. Human Pathology. 67, 160-8.
Retrieved from: https://www.sciencedirect.com/science/article/abs/pii/S0046817717302678 - Husain, A.N., et al. (2024, April 8). Guidelines for Pathologic Diagnosis of Malignant Mesothelioma: 2023 Update of the Consensus Statement from the International Mesothelioma Interest Group. Arch. Pathol. Lab. Med. 148(11), 1251-71.
Retrieved from: https://meridian.allenpress.com/aplm/article/148/11/1251/499833/Guidelines-for-Pathologic-Diagnosis-of - American Cancer Society. (2026, February 3). Early Detection, Diagnosis, and Staging of Mesothelioma.
Retrieved from: https://www.cancer.org/cancer/malignant-mesothelioma/detection-diagnosis-staging/how-diagnosed.html - Kim, K-C. and Vo, H-P. (2016, June). Localized Malignant Pleural Sarcomatoid Mesothelioma Misdiagnosed as Benign Localized Fibrous Tumor. J. Thorac. Dis. 8(6), E379-84.
Retrieved from: https://www.ncbi.nlm.nih.gov/pmc/articles/PMC4885954/ - Tan, W.W. (2024, December 16). Mesothelioima Treatment & Managment. Medscape.
Retrieved from: https://emedicine.medscape.com/article/1999348-overview - Mansfield, A.S., Symanowski, J.T., and Piekert, T. (2014, November). Systematic Review of Response Rates of Sarcomatoid Malignant Pleural Mesotheliomas in Clinical Trials. Lung Cancer. 86(2), 133-6.
Retrieved from: https://www.ncbi.nlm.nih.gov/pmc/articles/PMC4254081/pdf/nihms-625056.pdf - National Institutes of Health. (n.d.). Sarcomatoid Mesothelioma.
Retrieved from: https://clinicaltrials.gov/ct2/results?cond=sarcomatoid+mesothelioma


